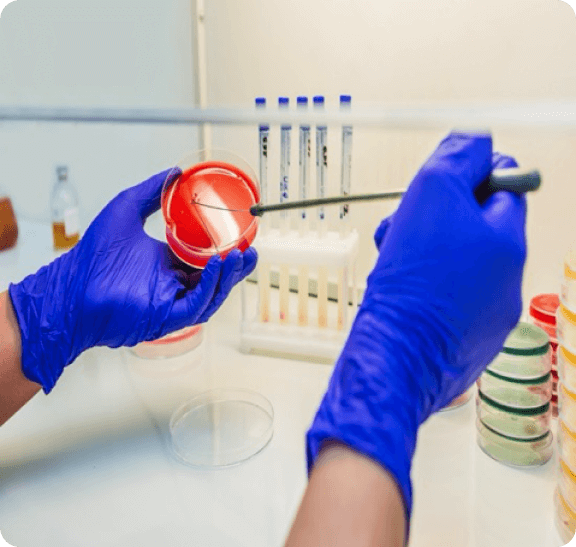
agrplmbkl1.png
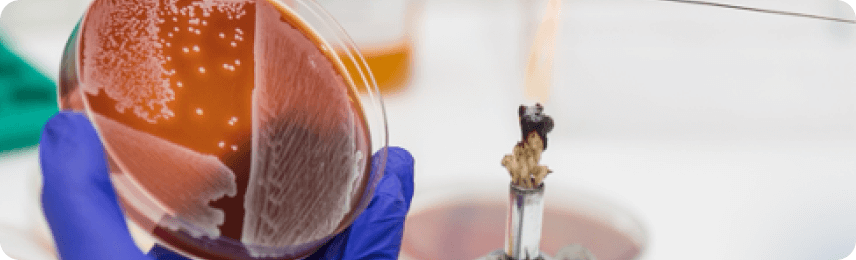
agrplmbkl2.png

Клиническая микробиология «АГРОПЛЕМ» — это высокоточные лабораторные решения для диагностики и контроля оппортунистических инфекций диких и домашних животных, а также птиц.
- Лабораторное подтверждение диагноза
-
Выделение и идентификация возбудителя
-
Дифференциация инфекции от контаминации
-
Подбор эффективной антимикробной терапии Исследуем широкий спектр биоматериала (кровь, выделения, мазки, органы и др.) — с акцентом на соблюдение стандартов отбора и быстроту получения результатов.
С нами здоровье ваших подопечных под надёжной защитой!
Раздел микробиологии, который изучает микробиологические аспекты оппортунистических инфекций диких и домашних животных, птиц, вызванных условно-патогенными микроорганизмами.
Оппортунистические инфекции — это инфекционные заболевания, которые обычно возникают на фоне нарушения противомикробного иммунитета.
Задачи клинической микробиологии:
-
Лабораторное подтверждение диагноза
Исследуемый материал
- Кровь
- Молоко
- Выделения (моча, мокрота, кал, помёт, сперма)
- Желудочное содержимое, двенадцатиперстной кишки
- Жёлчь
- Спиномозговая жидкость (ликвор)
- Бронхоальвеолярный лаваж (БАЛ)
- Экссудаты (жидкость, выпотевающая при воспалении из кровеносных сосудов в ткани и полости тела)
- Транссудаты (отѐчная жидкость, скапливающаяся в полостях тела вследствие нарушения крово — и лимфообращения)
- Пунктат (плевральный, перитонеальный, перекардиальный,содержимое абсцесса)
- Мазок с кожи, уха, со слизистой глаза, носа, зева, зоба, мочеполового тракта, прямой кишки, клоаки, раневое отделяемое
- Шерсть
- Паренхиматозные органы, абортивные плоды
Преаналитика
Результаты лабораторных исследований зависят от того, насколько правильно собран и доставлен в лабораторию материал.
Общие требования к отбору биоматериала
- Материал необходимо брать непосредственно из очага поражений.
- При взятии материала необходимо соблюдать правила личной безопасности и асептику. Обеспечение условий, исключающих контаминацию их за счёт смежных областей кожи, других органов и т.д.
- Брать материал необходимо до начала антибактериальной терапии При проведении антибактериальной терапии — отменить антибиотики за 14 дней до отбора материала.
- Материал следует брать в период наибольшего содержания в нем возбудителя заболевания, например кровь для выделения гемокультуры — в период лихорадки, гипотермии, лейкоцитоза.
- Количество материала должно быть достаточным для проведения исследования.
- Время между взятием материала и его исследованием должно быть максимально коротким
- Материал, подлежащий бак. исследованию, собирают в специализированные контейнеры, поставляемые лабораторией.